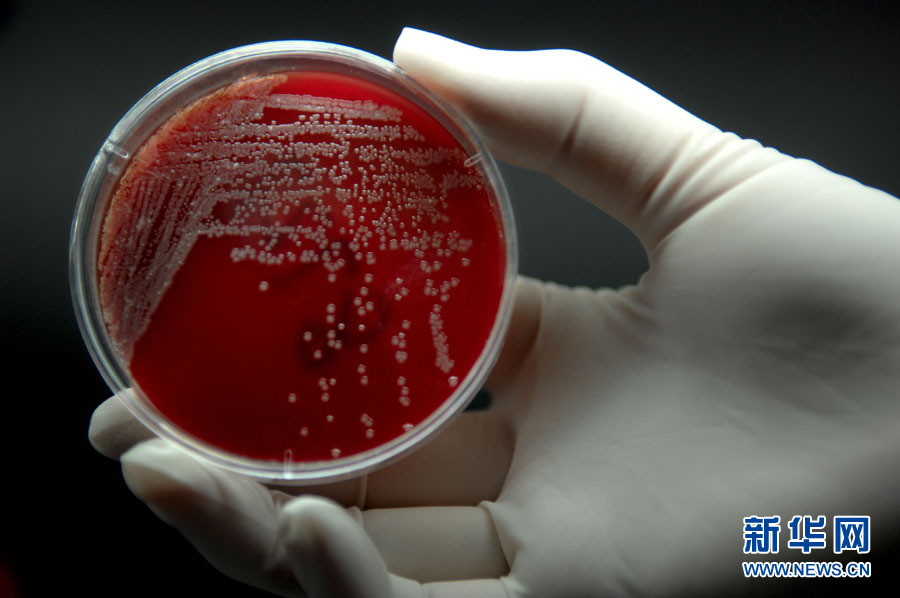

ĪĪĪĪØ·─Ž╩ąųąą─ßtį║▓ĪįŁ╬ó╔·╬’īWīŹ“×╩ę┼ÓB├¾ųąĄ─╝ÜŠ·Ż©10į┬29╚šözŻ®ĪŻØ·─Ž╩ąųąą─ßtį║╩Ūąl╔·▓┐┤_Č©Ą─╚½ć°19éĆ│¼╝ē╝ÜŠ·▒O£y╔┌³cßtį║ų«ę╗ĪŻŲõ▓ĪįŁ╬ó╔·╬’īWīŹ“×╩ę╝ńžōų°▒O£y│¼╝ē╝ÜŠ·Ą─ųž╚╬ĪŻÖz£y│¼╝ē╝ÜŠ·ąĶę¬Įø▀^╦─Ą└│╠ą“Ż║╣żū„╚╦åT╩ūŽ╚īóÅ─┼R┤▓╗╝š▀Ėą╚Š▓┐╬╗╠ß╚ĪĄ─śė▒ŠĘ┼į┌┼ÓB╗∙╔ŽĮėĘNŻ¼╚╗║¾į┘╦═╚ļČ■č§╗»╠╝┼ÓB╣±ųą▀Mąą18-24éĆąĪĢrĄ─┼ÓBĪŻ┼ÓB│÷╝ÜŠ·║¾Ż¼▀Mąą╝ÜŠ·ĶbČ©║═╦Ä╬’├¶Ėąąįįć“ׯ¼╚ń╣¹░l¼Fę╔╦Ų─═╦ÄąįĘ┤æ¬Ż¼Š═Ģ■īóŲõ╦═ĄĮĪ░┼R┤▓╗∙ę“öUį÷Öz“×īŹ“×╩ęĪ▒ū÷╗∙ę“Ęų╬÷Ż¼ūŅ┐ņā╔╚²╠ņŠ═┐╔ęį┤_šJ╩Ūʱ╩Ū│¼╝ē╝ÜŠ·ĪŻą┬╚A╔ńėøš▀ ╣∙Šw└ū öz
|